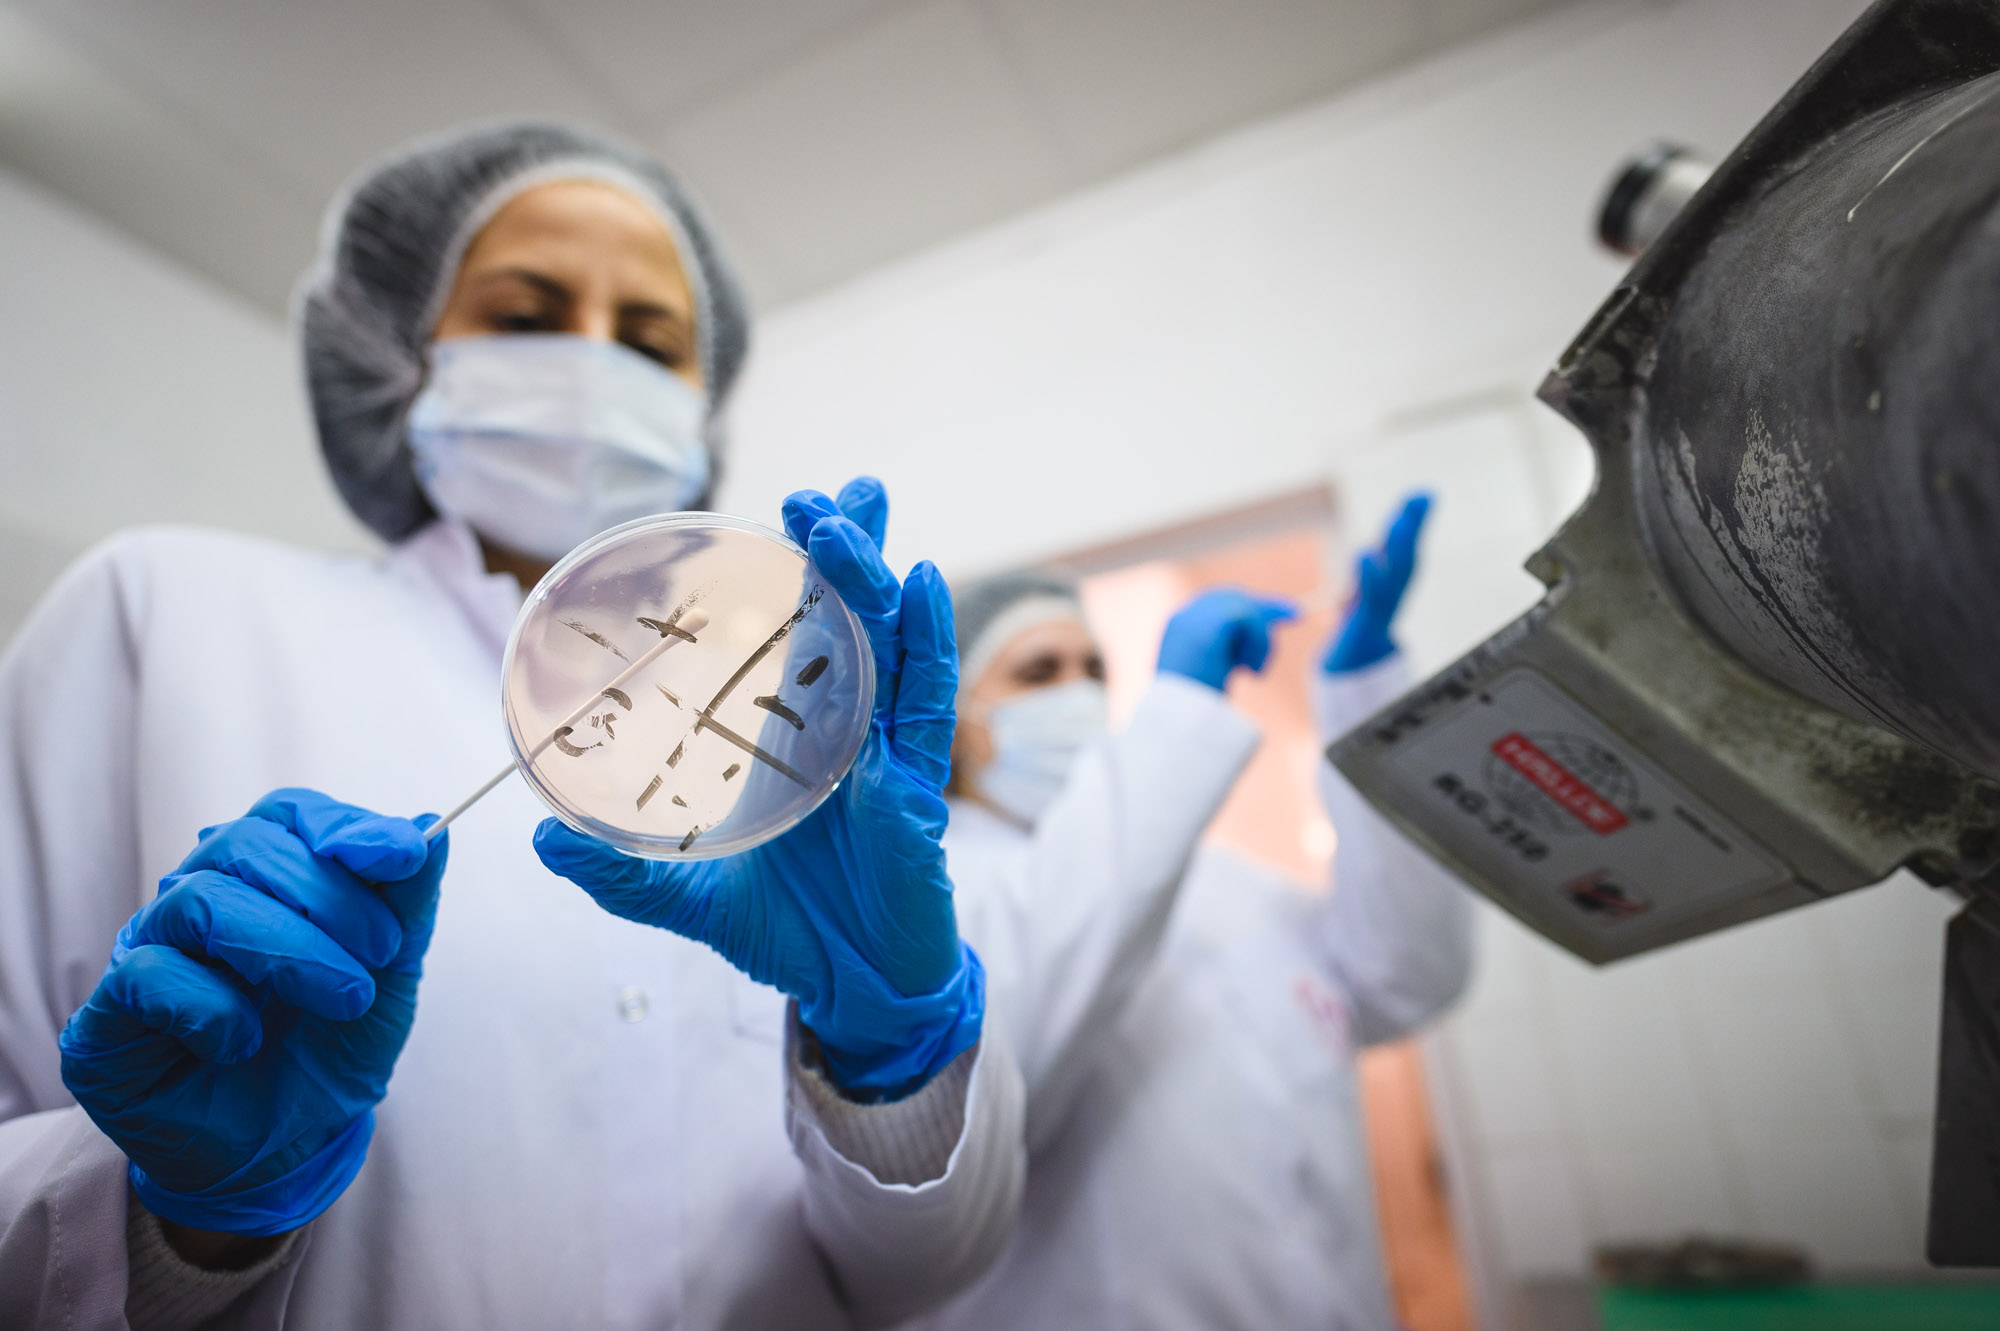

|
|
МЕДИЦИНА (При кандидатстване се изисква завършено средно образование)

|
Обучението по специалност „Медицина” (българоезично и англоезично обучение) отговаря на най-високите национални и международни стандарти. Осъществява се само в редовна форма, по учебен план, разработен на базата на единните държавни изисквания за специалността. Курсът на обучение е шест години. Той включва 10 учебни семестъра и преддипломен стаж, по време на който се полагат държавни изпити.След завършване на пълния курс на обучение студентите получават професионална квалификация „магистър-лекар” и придобиват образователно-квалификационна степен „магистър”.Дипломираните лекари могат да продължат своето медицинско образование чрез системата на специализация за получаване на желана от тях медицинска специалност.
Добрата подготовка на завършилите обучение в Медицински университет – Варна им предоставя възможност за много добра професионална реализация както в страната, така и в чужбина.
|
|
НАПРАВЛЕНИЕ "ВОЕНЕН ЛЕКАР" (При кандидатстване се изисква завършено средно образование)

|
Медицински университет „Проф. д-р Параскев Стоянов" – Варна, съвместно с Военномедицинска академия – София и Висше военноморско училище „Н. Й. Вапцаров", предлага възможност за обучение по направление „Военен лекар", което съчетава обучение по специалност „Медицина" за образователно-квалификационна степен „магистър" и специалност „Организация и управление на военни формирования на тактическо ниво", специализация „Медицинско осигуряване на въоръжените сили" с образователно-квалификационна степен „бакалавър". Обучението е в редовна форма и се провежда едновременно в МУ-Варна, ВМА и във ВВМУ. След завършване на пълния шестгодишен курс на обучение студентите получават образователно-квалификационните степени „магистър" по специалността „Медицина" от МУ-Варна и ОКС „бакалавър" по специалността „Организация и управление на военни формирования на тактическо ниво" от ВВМУ. Добрата подготовка на завършилите тази специалност им дава възможност за повишаване на квалификацията не само в България, но и във всички страни членки на НАТО.
|
|
ДЕНТАЛНА МЕДИЦИНА (При кандидатстване се изисква завършено средно образование)

|
Обучението по специалност „Дентална медицина” (българоезично и англоезично обучение) е само в редовна форма и се осъществява по учебен план, разработен на базата на единните държавни изисквания за специалността. През първите две години студентите получават медико-биологична подготовка. Клинико-медицинската подготовка се провежда от II до X семестър и включва профилирано обучение по общомедицински клинични дисциплини и специална подготовка по дентални дисциплини. Преддипломният стаж се извършва на цикли по: протетична дентална медицина; консервативно зъболечение; пародонтология и заболявания на оралната лигавица; орална и лицево-челюстна хирургия; детска дентална медицина; ортодонтия. Всеки цикъл завършва с държавен изпит.
Завършилите успешно пълния курс на обучение получават професионална квалификация „магистър-лекар по дентална медицина” и образователно-квалификационна степен „магистър”.
Виж повече,
Учебен план ,
Образуване на бала
|
|
ФАРМАЦИЯ (При кандидатстване се изисква завършено средно образование)

|
Обучението на студентите по "Фармация" е само в редовна форма и се осъществява по учебен план, разработен на базата на единните държавни изисквания за специалността и в съответствие с потребностите на фармацевтичния бизнес и изискванията на пазара на труда. Обучението е с продължителност пет години и се организира в три етапа. Първият етап осигурява фундаменталната подготовка на бъдещите фармацевти. През втория етап се изучават специални фармацевтични дисциплини с цел усвояване на знания и умения за упражняване на професията. Третият етап е преддипломен стаж, който се провежда в аптеки, утвърдени като бази за обучение. Обучението завършва след успешно полагане на държавни изпити. Дипломираните студенти получават професионална квалификация „магистър-фармацевт" и придобиват образователно-квалификационна степен „магистър".
|
|
МЕДИЦИНСКА СЕСТРА (При кандидатстване се изисква завършено средно образование)

|
Обучението по специалност „Медицинска сестра“ е в редовна форма с продължителност четири години и се провежда по учебен план и програми, отговарящи на единните държавни изисквания за специалността и на съвременните международни стандарти. Бакалавърската програма предоставя специфични знания, умения и компетентности за изпълнение на самостоятелни или съвместно с лекар дейности в различни сектори на здравеопазването, прилагайки комплексни грижи за физическото, психическото и социалното здраве. Завършилите специалността придобиват образователно-квалификационната степен „бакалавър“ и могат да се реализират професионално в лечебни заведения за болнична и извънболнична помощ, хосписи, детски ясли, детски градини, училищни здравни кабинети, регионални и национални центрове по обществено здраве и др. Възможност за дипломираните медицински сестри е и разкриване на автономни практики за оказване на здравни грижи за различни групи от населението.
Обучението по специалността „Медицинска сестра“ се провежда във Факултета по обществено здравеопазване в гр. Варна, както и във филиалите на университета в градовете Сливен, Шумен и Велико Търново.
|
НАПРАВЛЕНИЕ "ВОЕННА МЕДИЦИНСКА СЕСТРА" (При кандидатстване се изисква завършено средно образование)

|
Медицински университет „Проф. д-р Параскев Стоянов" – Варна (МУ-Варна), съвместно с Военномедицинска академия – София (ВМА) и Висшето военноморско училище „Н. Й. Вапцаров" (ВВМУ), предлага възможност за обучение по направление „Военна медицинска сестра", което съчетава обучение по специалност „Медицинска сестра" за образователно-квалификационна степен „бакалавър" и военна специалност „Медицинско осигуряване на въоръжените сили" с четвърта степен на професионална квалификация. Обучението е в редовна форма и се провежда едновременно в МУ-Варна, ВМА и във ВВМУ. След завършване на пълния четиригодишен курс на обучение студентите получават образователно-квалификационната степен „бакалавър" по специалността „Медицинска сестра" от МУ-Варна и четвърта степен на професионална квалификация по военна специалност „Медицинско осигуряване на въоръжените сили" в Професионалния старшински колеж на ВВМУ. Добрата подготовка на завършилите тази специалност им дава възможност за повишаване на квалификацията не само в България, но и във всички страни членки на НАТО.Подробна информация за обучението и възможностите за реализация може да бъде открита на интернет страницата на МУ-Варна: www.mu-varna.bg, и на ВВМУ: www.naval-acad.bg.
|
|
АКУШЕРКА (При кандидатстване се изисква завършено средно образование)

|
Обучението по специалност „Акушерка“ е в редовна форма с продължителност четири години и се провежда по учебен план и програми, отговарящи на единните държавни изисквания за специалността и на съвременните международни стандарти. Бакалавърската програма предоставя знания, формира умения, навици и компетентности, необходими за изпълнението на самостоятелни или във взаимодействие с лекар дейности при прилагане на комплексни грижи за здравето. Професията включва всички области на проследяване и лечение на неусложнена и усложнена бременност, раждане, следродилен и неонатален период, грижи при гинекологични заболявания, както и поддържане и запазване на репродуктивното здраве. Завършилите специалността придобиват образователно-квалификационната степен „бакалавър“ и могат да се реализират в лечебни заведения за болнична и извънболнична помощ и др. Възможност за дипломираните акушерки е разкриване на автономни практики за оказване на здравни грижи за различни групи от населението. Обучението по специалността „Акушерка“ се провежда във Факултета по обществено здравеопазване в гр. Варна, както и във филиалите на университета в градовете Сливен, Шумен и Велико Търново.
|
КИНЕЗИТЕРАПИЯ
(При кандидатстване се изисква завършено средно/висше образование)

|
Обучението по специалност „Кинезитерапия“ се провежда в две образователно-квалификационни степени (ОКС): „бакалавър“ и „магистър“. Обучението по специалност „Кинезитерапия" за образователно-квалификационна степен „бакалавър" е в редовна форма и се осъществява по учебен план, разработен на базата на единните държавни изисквания за специалността. Продължителността на обучението е четири години (осем семестъра) и завършва с държавен изпит. Организацията на учебния процес съчетава академичното обучение с придобиването на специфични за професионалното направление теоретични и практически умения, като се акцентира върху качеството на практическото обучение. Основната цел на обучението е да се подготвят специалисти, необходими за кинезитерапевтичната практика в системата на здравеопазването, в обществения и в частния сектор. Обучението в ОКС „магистър“ по кинезитерапия е предназначено за професионалисти с ОКС „бакалавър“ по същата специалност и е с продължителност една година (два семестъра) в редовна форма, на базата на единните държавни изисквания. Обучението завършва с полагане на държавен изпит или защита на дипломна работа. Професионалната реализация на завършилите магистърска програма по специалност „Кинезитерапия“ предоставя възможност за реализация в различни структури за осъществяване на функционално-диагностична, профилактична, терапевтична, рекреативна и рехабилитационна дейност.
Учебен план, Образуване на бала |
ЗДРАВЕН
МЕНИДЖМЪНТ (При кандидатстване се изисква завършено средно/висше образование)
 |
Специалността отговаря на потребностите от професионална компетентност в областта на администрацията и управлението в здравеопазването и свързаните с него сфери на обществения живот. Основната цел е подготовката на специалисти, които са в състояние да участват в изследването и решаването на административни и управленски проблеми и във вземането на управленски решения на средни и висши нива на управления в организации и институции, работещи в здравеопазването. Обучението е насочено към придобиване на две образователно-квалификационни степени: „бакалавър“ и „магистър“. Обучението за степен „бакалавър“ е в редовна форма с продължителност четири години (осем семестъра) и завършва с полагане на държавен изпит. Обучението за степен „магистър“ след бакалавър по същата специалност е в задочна форма с продължителност една година (два семестъра) и завършва с полагане на държавен изпит или защита на дипломна работа. Обучението за степен „магистър“ след „бакалавър“ или „магистър“ по друга специалност е в задочна форма с продължителност две години (четири семестъра) и завършва с полагане на държавен изпит или защита на дипломна работа. Мултидисциплинарната програма обхваща дисциплини от областта на управленските, здравните, икономическите, социалните и правните науки. Организацията на учебния процес съчетава академичното обучение с придобиването на специфични за професионалното направление и приложното му поле практически умения и компетентности. Разнообразните методи на обучение включват лекции, работа в малки групи, работни симулации, решаване на казуси и задачи, работа по екипни задания, ролеви игри, разработване на курсови работи и участие в изследователски проекти. По време на обучението се провеждат срещи с успешни професионалисти от здравеопазването и свързаните с него сфери на дейност и се организират посещения в здравни организации и институции. В края на четвъртата година на бакалавърската програма се провежда преддипломен стаж. Завършилите специалността се реализират успешно на различни управленски нива в лечебни и здравни заведения, както и в други организации и институции, работещи в здравеопазването и свързаните с него сфери на дейност.
|
|
ЗДРАВЕН МЕНИДЖМЪНТ И МЕДИКО-СОЦИАЛНИ ГРИЖИ (При кандидатстване се изисква завършено висше образование)

| Магистърската програма е проектирана да отговори на специфичните потребности от висококвалифицирани професионалисти в областта на администрацията и управлението на организации, институции и дейности в системата на здравеопазването и медико-социалните грижи. Специфичното съчетание от знания и умения, съобразени със съвременните тенденции в развитието на здравния мениджмънт, медико-социалните грижи и здравеопазването като цяло, дават възможност на завършилите студенти да се реализират успешно на различни административни позиции и управленски равнища. Магистърската програма се провежда в задочна форма с продължителност две години (четири семестъра). Обучението включва лекционни курсове, дискусии, решаване на практически задачи и казуси, консултации и разработване на курсови проекти. По време на следването се организират срещи с професионалисти от практиката и се провеждат посещения в организации и институции от здравната и социалната сфера. Магистърската програма завършва с полагане на държавен изпит или защита на дипломна работа за придобиване на образователната и квалификационна степен „магистър“ по здравен мениджмънт и медико-социални грижи. Мултидисциплинарният профил на програмата комбинира дисциплини от научните области на медицинските и обществените науки. Структурата и съдържанието на магистърската програма осигуряват необходимите теоретични знания и практически умения, формиращи професионална компетентност за работа на административни и управленски позиции на всички равнища на здравната система и медико-социалните грижи, както и за експертна и консултантска дейност.
|
ЛОГОПЕДИЯ
(При кандидатстване се изисква завършено средно/висше образование)
 |
Обучението по специалност „Логопедия“ се провежда в две образователно-квалификационни степени (ОКС): „бакалавър“ и „магистър“. Обучението по специалност „Логопедия“ за образователно-квалификационна степен „бакалавър“ се провежда в редовна форма с продължителност четири учебни години. Завършилите придобиват професионална квалификация „логопед“ (говорен терапевт) и могат да провеждат езиково-говорна терапия при деца и възрастни.
В периода на обучение студентите изучават логопедични, медицински, психологически, педагогически и други дисциплини, даващи знания, умения и компетентности за осъществяване на терапевтична, корекционна, методическа и изследователска дейност. Практическата подготовка се осъществява в утвърдени бази за обучение – болнични заведения, образователни институции, дневни центрове и др. Дипломираните имат възможност да практикуват самостоятелно или в екип, да се реализират в болничната и извънболничната помощ, в различните видове социални центрове в общността, служби за психично здраве; специализирани логопедични кабинети и центрове – частни и държавни към предучилищни и училищни заведения; центрове за деца с нарушения в развитието; центрове за социална рехабилитация и др. Магистърската програма по „Логопедия“ е предназначена за специалисти с образователно-квалификационна степен „бакалавър“ от професионални направления: 1.2 „Педагогика“, 1.3 „Педагогика на обучението по...“, 2.1 „Филология“ и 3.2 „Психология“. В програмата могат да кандидатстват и лица с образователно-квалификационна степен „магистър“ след завършено средно образование от професионални направления 7.1 „Медицина“ и 7.2 „Дентална медицина“. Проектирана е да отговори на специфичните потребности на пазара на труда в областта на езиковата и речевата патология в здравната, образователната и социалната сфери. Програмата дава възможност за преквалификация чрез придобиване на нови знания и умения за прилагане на специфични методи за логопедична корекция на езиково-говорни нарушения при деца и възрастни. В процеса на обучението студентите придобиват знания за използване на съвременните технологии в професионалната им дейност. Обучението акцентира върху екипния и мултидисциплинарния подход в диагностиката и терапията на речевата и езиковата патоло гия и на новите постижения в областта на логопедията, както и практики, базирани на доказателства. Обучението се провежда в задочна форма с продължителност две учебни години и завършва с полагане на държавен изпит или защита на дипломна работа. Завършилите придобиват образователно-квалификационна степен „магистър“ с професионална квалификация „логопед“ (говорен терапевт) и имат възможност да практикуват самостоятелно или в екип. Професията позволява реализация в болничната и извънболничната помощ, в различните видове социални центрове в общността, служби за психично здраве; специализирани логопедични кабинети и центрове – частни и държавни; към предучилищни и училищни заведения; центрове за деца с нарушения в развитието; центрове за социална рехабилитация и др. Завършилите програмата могат да продължат образованието си в образователна и научна степен „доктор".
Учебeн план, Образуване на бала
|
БИОМЕДИЦИНСКА ТЕХНИКА И ТЕХНОЛОГИИ (При кандидатстване се изисква завършено средно образование)

| Специалността „Биомедицинска техника и технологии“ има за цел да подготвя висококвалифицирани специалисти с интердисциплинарна подготовка за практическа и изследователска работа в областта на развитието, приложението и поддържането на специфични за здравеопазването и клиничната дейност апаратура, софтуерни продукти и информационни масиви, както и методи за моделиране и за обработка на медицински изображения и симулации. Учебният план включва задължителни дисциплини от научните области на инженерните, информационните и медицинските науки, формиращи специалисти с интердисциплинарна подготовка, както и избираеми и факултативни дисциплини, от които студентите могат да избират в зависимост от интересите си. Обучението е в редовна и задочна форма с продължителност осем семестъра и завършва с полагане на държавен изпит или защита на дипломна работа. Завършилите курса на обучение придобиват образователно-квалификационна степен „бакалавър“ с професионална квалификация „инженер по биомедицинска техника и технологии“.
Полученото висше образование позволява на инженера по биомедицинска техника и технологии да работи като консултант, сътрудник по технически въпроси, поддръжка на медицинска техника и др. в различни лечебни заведения, фирми за производство, поддръжка и търговия с медицинска техника, контролно-аналитични лаборатории и научноизследователски организации и др.
|
|
УПРАВЛЕНИЕ НА ЗДРАВНИ ГРИЖИ (При кандидатстване се изисква завършено висше образование)
 |
Обучението по специалност „Управление на здравните грижи“ се провежда в две ОКС: „бакалавър“ и „магистър“, в задочна форма. Учебният план за ОКС „бакалавър“ е разработен на базата на единните държавни изисквания за специалността и гарантира придобиване на висока теоретична и практическа подготовка в професионалните направления: „ръководител на здравните грижи“ и „преподавател по практика“. Продължителността на обучението е пет семестъра. През последния семестър се провежда преддипломен стаж по управление на здравните грижи и педагогика. Придобиването на ОКС „бакалавър“ завършва с два държавни изпита – теоретичен и практически.
Обучението за ОКС „магистър“ се осъществява по два учебни плана: за професионалисти, притежаващи ОКС „бакалавър“ по същата специалност, с продължителност два семестъра; и за професионалисти, притежаващи ОКС „бакалавър“ по друга специалност, с продължителност три семестъра. Организацията на учебния процес е насочена към придобиване специфични знания, умения и компетентности в сферата на управлението на здравните грижи и преподавателската практика. Придобиването на ОКС „магистър“ завършва след успешно полагане на държавен изпит или защита на дипломна работа.
Завършилите специалността получават професионална квалификация и в двете взаимно допълващи се направления: „ръководител на здравните грижи“ и „преподавател по практика“. Те могат да се реализират като ръководители на здравните грижи в различни лечебни, здравни и социални заведения, като асистенти във висше училище по специалностите „Медицинска сестра“ и „Акушерка“, както и като преподаватели по практика в медицински колежи.
|
ФАРМАЦЕВТИЧЕН МЕНИДЖМЪНТ (При кандидатстване се изисква завършено висше образование)
|
Магистърската програма по фармацевтичен мениджмънт е насочена към специфичните потребности на бързо развиващия се фармацевтичен сектор в България от висококвалифицирани професионалисти по управление, както и на потребностите от развитие на организационната култура във фармацевтичните компании. Програмата интегрира науките в областта на бизнеса и фармацията, създавайки по този начин професионалисти за фармацевтичния сектор от ново поколение. Магистърската програма по фармацевтичен мениджмънт е в задочна форма и с продължителност четири семестъра (две учебни години). Обучението включва лекционни курсове, практически упражнения, консултации и самостоятелна подготовка. По време на следването се организират редовни срещи с успешни професионалисти от фармацевтичния бизнес и се провеждат посещения във фармацевтични фирми и други организации, свързани със здравеопазването. Магистърската програма завършва с полагане на държавен изпит или защита на дипломна работа за придобиване на образователно-квалификационна степен „магистър“ по фармацевтичен мениджмънт. Професионалната реализация на завършилите е свързана с различни административни и управленски позиции във фармацевтични фирми, организации, чиято дейност е свързана с фармацевтичния сектор, и органи на държавната администрация. Програмата е подходяща за магистри по фармация, медицина, дентална медицина, бакалаври и/или магистри по управление и други области на висшето образование, с изключение на придобилите специалност от професионално направление 7.5 „Здравни грижи“ и придобилите ОКС „бакалавър“ по специалността „Кинезитерапия“.
Учебен план, Образуване на бала
|
|
ФАРМАЦЕВТИЧЕН МЕНИДЖМЪНТ И ГРИЖИ (При кандидатстване се изисква завършено висше образование)

|
Магистърската програма „Фармацевтичен мениджмънт и грижи“ е създадена да отговори на специфичните потребности на фармацевтичния сектор в България от висококвалифицирани професионалисти с интердисциплинарна подготовка, ориентирана към икономическите и управленските аспекти на лекарствоснабдяването и фармацевтичните грижи. Специфичното съчетание от знания и умения, съобразени със съвременните тенденции в развитието на фармацевтичния сектор и здравеопазването като цяло, дават възможност на завършилите студенти да бъдат част от интердисциплинарни екипи на различни административни позиции и управленски равнища. Магистърската програма се провежда в задочна форма с продължителност две години (четири семестъра). Обучението включва лекционни курсове, дискусии и решаване на практически задачи и казуси, консултации, работа в екип, работни симулации и разработване на курсови проекти. По време на следването се организират срещи с успешни професионалисти от фармацевтичния бизнес и се провеждат посещения във фармацевтични фирми и други организации, свързани със здравеопазването. Обучението завършва с полагане на държавен изпит или защита на дипломна работа за придобиване на образователната и квалификационна степен „магистър“ по фармацевтичен мениджмънт и грижи. Програмата съчетава дисциплини от различни области на обществените и здравните науки с насоченост към фармацевтичния сектор и фармацевтичните грижи.
Завършилите специалността се реализират успешно като част от интердисциплинарни екипи на различни административни позиции и управленски равнища в организации и институции, свързани с фармацевтичния сектор. Програмата е подходяща за професионални бакалаври по специалност „Помощник-фармацевт“, както и професионални бакалаври от други специалности в професионално направление 7.5 „Здравни грижи“. |
|
РЕХАБИЛИТАЦИЯ, МОРЕЛЕЧЕНИЕ, УЕЛНЕС И СПА
(При кандидатстване се изисква завършено висше образование) 
|
Магистърската програма „Рехабилитация, морелечение, уелнес и СПА“ е проектирана да отговори на потребностите на бързо развиващите се оздравителни и уелнес пазари в България от висококвалифицирани професионалисти за сектора. Програмата е предназначена за специалисти с полувисше образование (тригодишен курс на обучение) или с ОКС „професионален бакалавър" по специалността „Рехабилитатор"; с ОКС „бакалавър" или „магистър" по специалността „Кинезитерапия"; с ОКС „бакалавър" или „магистър" от област на висшето образование „7. Здравеопазване и спорт", с професионален практически опит в областта. Обучението е в задочна форма, с продължителност две години (четири семестъра) и завършва с полагане на държавен изпит или защита на дипломна работа.
|
ОПАЗВАНЕ И КОНТРОЛ НА ОБЩЕСТВЕНОТО ЗДРАВЕ
(При кандидатстване се изисква завършено висше образование)

|
Магистърската програма „Опазване и контрол на общественото здраве" е насочена към потребностите на здравните професионалисти с полувисше образование (тригодишен курс на обучение) или с ОКС „професионален бакалавър по ..." по специалност от професионално направление 7.5 „Здравни грижи", както и придобилите висше образование в ОКС „бакалавър" или „магистър". Тя разширява познанията в областта на съвременните глобални и специфични проблеми на общественото здраве, повишава квалификацията и професионалните умения за превенция и ограничаване разпространението на заразни и социалнозначими заболявания, за здравно обучение и промоция на здраве. Учебният план е съобразен с препоръките на Европейската асоциация на училищата по обществено здравеопазване (ASPHER) относно компетенциите на професионалистите по обществено здравеопазване. Обучението е в задочна форма, с продължителност две години (четири семестъра) и завършва с преддипломен стаж, полагане на държавен изпит или защита на дипломна работа.
Завършилите студенти могат да се реализират в регионални здравни инспекции; областни дирекции към Агенцията по безопасност на храните; подразделения на Министерството на вътрешните работи, осъществяващи контролни функции в областта на общественото здраве; служби по трудова медицина; органи на граничния контрол; служби за контрол на вътреболничните инфекции; фирми по дезинсекция, дезинфекция и дератизация; в промишлени предприятия като специалисти по безопасност и здраве при работа и др. Програмата е подходяща за професионални бакалаври по специалност „Инспектор по обществено здраве“, както и професионални бакалаври от други специалности в професионално направление 7.5 „Здравни грижи“ и бакалаври и/или магистри от други специалности.
Учебен план,
Образуване на бала |
ОПТОМЕТРИСТ (При кандидатстване се изисква завършено висше образование)
 | Специалността "Оптометрист" с ОКС "Магистър" е насочена към потребностите на обществото от специалисти, полагащи грижи за очното здраве, и даваща възможност за кариерно развитие на професионалните бакалаври "Медицински оптик" и бакалаврите оптометристи. Основните цели на обучението по специалността са насочени към надграждане на фундаменталните познания и придобиване на специализирани умения за диагностика и опазване на очното здраве. Акцентите на практическата подготовка са върху съвременни диагностични технологии, средства за оптична корекция и специфични познания за напасване на контактни лещи. Програмите са съобразени с най-добрите европейски и световни практики. В процеса на обучение се осигурява подготовка за научноизследователска дейност. Програмата е в редовна форма на обучение с продължителност две години (четири семестъра) и завършва с държавен изпит или защита на дипломна работа. Магистрите по оптометрия са медицински специалисти, полагащи грижа за очното здраве с насоченост към оптичната корекция и профилактика на очните заболявания. |
ИНФОРМАЦИОННИ ТЕХНОЛОГИИ В ЗДРАВЕОПАЗВАНЕТО И ЗДРАВНИТЕ ГРИЖИ
(При кандидатстване се изисква завършено висше образование)

| Подготовката по магистърската програма е многопрофилна и осигурява придобиване на фундаментални и специализирани теоретични знания в областта на информационните, здравните и социалните науки. Професионалната квалификация на магистрите е в областта на компютърните и информационните технологии, прилагани в здравеопазването и здравните грижи: софтуерни продукти в здравния сектор, информационни медицински и здравни масиви и бази данни, методи и приложения за обработка на медицински изображения и компютърни модели на човешки тъкани и органи, 3D принтиране, софтуерни приложения за предоставяне на здравни грижи, приложни програмни среди за симулации в научноизследователската работа. Обучаващите се в специалността задълбочават своите познания в различни аспекти на здравеопазния процес и здравните грижи, придобиват умения за самостоятелно създаване на приложения и скриптове за обработка на биомедицински данни и изображения, идентифициране, дефиниране и разрешаване на проблеми, свързани с информационното осигуряване на управленския процес в здравеопазването и здравните грижи, което се съчетава със знания и умения за анализ и представяне на данни и умения за работа в интердисциплинарни екипи. Обучението е в задочна форма с продължителност две години (четири семестъра) и завършва с полагане на държавен изпит или защита на дипломна работа. За магистърската програма могат да кандидатстват специалисти с ОКС „професионален бакалавър“ по специалността „Рентгенов лаборант“ или по-висока ОКС по специалност от професионално направление 7.5 „Здравни грижи“. Магистрите по информационни технологии в здравеопазването и здравните грижи могат да се реализират във фирми за разработване и внедряване на информационни технологии в медицината и здравеопазването, фирми за производство и поддръжка на компютъризирана медицинска техника, лечебни и здравни заведения и фармацевтични фирми, здравноосигурителни организации, консултантски и експертни организации, работещи в областта на управлението и информационните технологии в здравеопазването и др.
Учебен план, Образуване на бала
|
ЕЛЕКТРОННИ И ИНФОРМАЦИОННИ ТЕХНОЛОГИИ В ЗДРАВЕОПАЗВАНЕТО (При кандидатстване се изисква завършено висше образование)

|
Магистърската програма „Електронни и информационни технологии в здравеопазването“ в професионално направление 5.2. „Електротехника, електроника и автоматика“ е проектирана да отговори на специфичните потребности на здравния сектор в България от висококвалифицирани професионалисти с професионалната квалификация в областта на електронните, компютърни и информационните технологии, прилагани в здравеопазването: информационни системи в медицината и здравеопазването, приложни симулационни продукти, компютърна обработка на медицински сигнали и изображения, софтуерни приложения за 3D принтиране, софтуерни приложения за здравеопазването, компютърни технологии и системи, медицинска техника, оптоелектронна и лазерна техника. Обучението е насочено към професионалисти с ОКС „бакалавър“ или „магистър“, чиито интереси или професионална реализация са свързани с приложението и развитието на електронните, компютърните и информационните технологии в здравеопазването. Обучението е в задочна форма с продължителност: - една година (два семестъра) след придобита ОКС „бакалавър“ или „магистър“ по професионално направление 5.2 „Електротехника, електроника и автоматика“; - две години (четири семестъра) за професионалисти с ОКС „бакалавър“ или „магистър“ по други професионални направления, различни от професионално направление 5.2. „Електротехника, електроника и автоматика“. Програмата завършва с полагане на държавен изпит или защита на дипломна работа.
Завършилите курса на обучение могат да се реализират във фирми за разработване и внедряване на информационни технологии в медицината и здравеопазването, фирми за производство и поддръжка на компютризирана медицинска техника, лечебни и здравни заведения и фармацевтични фирми, органи на държавната администрация с контролни и регулаторни функции в здравеопазването, научноизследователски и учебни заведения, консултантски и експертни организации, работещи в областта на управлението и информационните технологии в здравеопазването.
|
КЛИНИЧНА ЛОГОПЕДИЯ
(При кандидатстване се изисква завършено висше образование)

|
Магистърската програма „Клинична логопедия“ е предназначена за специалисти по „Логопедия“ с образователно-квалификационна степен „бакалавър“ или „магистър“ от професионално направление 7.4 „Обществено здраве“. Тя е проектирана да отговори на специфичните потребности на пазара на труда в областта на езиковата и речева патология в здравната, образователната и социалната сфери. Магистратурата е ориентирана към придобиване на нови знания и умения за прилагане на специфични методи за логопедична корекция на езиково-говорни нарушения при деца и възрастни. В процеса на обучението студентите придобиват нови знания за използване на съвременните технологии в професионалната им дейност. Обучението акцентира върху екипния и мултидисциплинарния подход в диагностиката и терапията на речевата и езикова патология и на новите постижения в областта на клиничната логопедия. Магистърската програма е организирана в два семестъра, провежда се в задочна форма на обучение и завършва с полагане на държавен изпит или защита на дипломна работа. Завършилите програмата могат да продължат образованието си в образователна и научна степен „доктор".
|
|
СПЕЦИАЛНОСТИ В МЕДИЦИНСКИ КОЛЕЖ - ВАРНА
Висшето образование по тези специалности е за придобиване на образователно-квалификационна степен „професионален бакалавър по ...". Обучението е само в редовна форма с продължителност три учебни години.
|
|
МЕДИЦИНСКИ ЛАБОРАНТ (При кандидатстване се изисква завършено средно образование)

|
Медицинският лаборант е здравен специалист, подготвен да работи във всички видове лечебно-диагностични и научноизследователски лаборатории. Обект на неговата дейност са клинико-лабораторни, хистологични, микробиологични, вирусологични, генетични, имунологични, паразитологични и други изследвания. Лабораторното изследване е част от сложния диагностичен процес, което изисква отлична подготовка, издръжливост и отдаденост. Като професионалисти по здравни грижи, медицинските лаборанти работят под ръководството на лекари със съответната специалност и са важен ресурс в целия процес.
Обучението е с практическа насоченост, което изгражда професионализъм и развива ценни умения.
Завършилите студенти намират много добра реализация в различни лабораторни звена като клинична лаборатория, микробиология, вирусология, хистология, медицинска генетика, паразитология, имунология и др. Могат да продължат обучението си в магистърските програми на МУ-Варна „Здравен мениджмънт и медико-социални грижи“, „Опазване и контрол на общественото здраве“ и „Фармацевтичен мениджмънт и грижи“.
Учебен план ,
Образуване на бала
|
|
ПОМОЩНИК - ФАРМАЦЕВТ (При кандидатстване се изисква завършено средно образование)
|
Помощник-фармацевтът е здравен специалист, който участва активно в лекарствопроизводството и лекарствоснабдяването. Той приготвя и отпуска лекарствени форми, билкови смеси, санитарно-хигиенни материали, козметични средства, диетични продукти и други в рамките на компетенциите си под контрола на магистър фармацевт или самостоятелно. Въз основа на придобитите теоретични знания и практически умения по време на обучението, помощник-фармацевтът има следните широки възможности за професионална реализация: аптека за отпускане на лекарства на граждани, билкова аптека, аптека на лечебно заведение, аптечни складове, фармацевтични фирми, фармацевтични заводи, галено-фасовъчни лаборатории, дрогерии, магазини за медицински изделия, научноизследователски институти, висши училища. Упражняването на професията „помощник-фармацевт“ е свързано с поемане на фундаментални отговорности, осигуряване на фармацевтични грижи, прилагане на промоция на здравето и профилактика на заболяванията.Завършилите студенти могат да продължат обучението си в магистърските програми на МУ-Варна „Фармацевтичен мениджмънт и грижи“, „Опазване и контрол на общественото здраве“ и „Здравен мениджмънт и медико-социални грижи“.
Учебен план ,
Образуване на бала |
|
ИНСПЕКТОР ПО ОБЩЕСТВЕНО ЗДРАВЕ (При кандидатстване се изисква завършено средно образование)
|
Обучението по специалността насочено към изграждане на специалисти, които осъществяват държавен здравен контрол с цел опазване и укрепване на общественото здраве в Република България. Това е държавна здравна дейност, свързана с изпълнение на установените с нормативен акт здравни изисквания за: контрол на обекти с обществено предназначение; контрол на продукти, стоки и дейности със значение за здравето на човека; контрол на условията на жизнената среда; надзор на заразните болести. Освен контролна дейност, свързана с изпълнение на установените с нормативни актове здравни изисквания, инспекторите по обществено здраве имат и консултантски функции. Те запознават обществеността със специфичните здравни рискове и стратегии, подпомагащи здравословния начин на живот и намаляващи риска от развитие на болести. Завършилите студенти могат да се реализират в регионални здравни инспекции; областни дирекции към Агенцията по безопасност на храните; подразделения на Министерство на вътрешните работи, осъществяващи контролни функции в областта на общественото здраве; служби по трудова медицина; органи на граничния контрол; служби за контрол на вътреболничните инфекции; фирми по дезинсекция, дезинфекция и дератизация; промишлени предприятия, като специалисти по безопасност и здраве при работа и др. Съществуват възможности за продължаване на обучението в магистърските програми на МУ-Варна „Опазване и контрол на общественото здраве“, „Здравен мениджмънт и медико-социални грижи“ и „Фармацевтичен мениджмънт и грижи“. |
|
ЗЪБОТЕХНИК (При кандидатстване се изисква завършено средно образование)

|
Зъботехникът е здравен специалист, който е част от екип, ръководен от лекар по дентална медицина. Той изработва зъбопротезни конструкции, ортодонтски апарати и ортопедични шини, в специализирани здравни заведения, наречени зъботехнически лаборатории. Дигиталните технологии предоставят нови възможности, свързани с оптимизирането и автоматизирането на определени аспекти на работния процес. Получилият професионална квалификация ,,зъботехник“ може да работи в зъботехнически лаборатории в България и в чужбина, както и да разкрива своя собствена.
Завършилите студенти могат да продължат обучението си в магистърските програми на МУ-Варна „Здравен мениджмънт и медико-социални грижи“, „Опазване и контрол на общественото здраве“ и „Фармацевтичен мениджмънт и грижи“.
Учебен план ,
Образуване на бала
|
РЕХАБИЛИТАТОР (При кандидатстване се изисква завършено средно образование)

|
Целта на обучението по специалността „Рехабилитатор" е студентите да получат теоретична и практическа подготовка за ранна превенция на развитието на болестите и техните усложнения, максимално възстановяване на заболяванията с оглед подобряване качеството на живот на пациентите. Рехабилитаторът е специалист, който има право да работи в медицински центрове, диагностично-консултативни центрове, многопрофилни болници, санаториални центрове, центрове за продължително долекуване, спа курортни центрове, социални заведения за деца с увреждания, спортни клубове и спортни бази, центрове за красота. Придобилите специалността получават знания и умения, както в прилагането на кинезитерапевтичните методи и средства, така и в методите на електролечение, светлолечение, водотоплотерапия, климато-балнеотерапия и специална физиотерапия. Съществуват възможности за продължаване на обучението в магистърските програми на МУ-Варна „Рехабилитация, морелечение, уелнес и спа“, „Здравен мениджмънт и медико-социални грижи“, „Опазване и контрол на общественото здраве“ и „Фармацевтичен мениджмънт и грижи“.
|
|
РЕНТГЕНОВ ЛАБОРАНТ (При кандидатстване се изисква завършено средно образование)

|
Целта на обучението на рентгеновите лаборанти е да се подготвят специалисти, които да прилагат самостоятелно и/или под ръководство методи и техники на образната диагностика, нуклеарната медицина и лъчелечението. Това включва: конвенционална рентгенова диагностика, ултразвукова диагностика, високоспециализирани рентгенови техники: компютърна томография, мамография, магнитен резонанс и интервенционални методи. Усвояват се съвременни методи за диагностика и лечение, използвани в нуклеарната медицина като PET-CT и гама-камера, както и методи и техники за лъчелечение на онкологични и неонкологични заболявания чрез използване на линейни ускорители и радиохирургия. Завършилите студенти могат да продължат обучението си в магистърските програми на МУ-Варна „Информационни технологии в здравеопазването и здравните грижи“, „Здравен мениджмънт и медико-социални грижи“, „Опазване и контрол на общественото здраве“ и „Фармацевтичен мениджмънт и грижи“.
Учебен план ,
Образуване на бала |
|
МЕДИЦИНСКИ КОЗМЕТИК (При кандидатстване се изисква завършено средно образование)

|
Медицинският козметик е здравен специалист с подготовка в областта на козметологията, дерматологията, пластичната хирургия, фармацията, физикалната терапия. Основният фокус по време на обучението е практическата подготовка. Периодично се организират мастър класове за работа с високотехнологична апаратура и иновативна козметика. Завършилите тази специалност могат да работят в козметично студио, в салон или център за красота, в екип в дерматологични и дерматокозметични центрове, клиники по пластична хирургия, дрогерии и парфюмерии, балнео-, уелнес, спа и таласотерапевтични центрове. Съществуват възможности за продължаване на обучението в магистърските програми на МУ-Варна „Здравен мениджмънт и медико-социални грижи“, „Опазване и контрол на общественото здраве“ и „Фармацевтичен мениджмънт и грижи“.
Учебен план ,
Образуване на бала
|
|
МЕДИЦИНСКИ ОПТИК (При кандидатстване се изисква завършено средно образование)

|
Медицинският оптик е специалист по медицинска оптика и оптична корекция на зрението и може да работи във всички оптики, оптични центрове, работилници и заводи, складове за оптични средства и офталмологични практики. Медицинският оптик е квалифициран да оценява, изработва и препоръчва оптични средства, както и да дава консултации по проблемите на зрението, включително зрителна рехабилитация, превенция и профилактика. В зависимост от обема на работата и сложността на проблема може да работи самостоятелно или под ръководството на лекар, специалист по очни болести. При работа под ръководство, медицинският оптик може да извършва и редица високотехнологични изследвания. Теоретическата и практическата подготовка по време на обучението е насочена към усвояване на задълбочени познания в следните насоки: фундаментални медико-биологични знания и детайлна подготовка по оптика, физична и клинична рефракция; специални медицински знания и умения по оптика; организационно-управленски знания и умения; комуникативни, етични, научно-изследователски, законови и др. Подготовката на студентите включва всички базови познания за работа като техник по очна оптика, както и нужните медицински познания с цел да се отговори на Закона за здравето и да се осигури възможност за компетентна консултация по проблемите на зрението. Завършилите студенти могат да продължат обучението си в магистърските програми на МУ-Варна „Оптометрист“, „Здравен мениджмънт и медико-социални грижи“, „Опазване и контрол на общественото здраве“ и „Фармацевтичен мениджмънт и грижи“.
Учебен план ,
Образуване на бала
|
|
СПЕЦИАЛНОСТИ ВЪВ ФИЛИАЛИТЕ В ГРАДОВЕТЕ СЛИВЕН, ШУМЕН И ВЕЛИКО ТЪРНОВО |
|
АКУШЕРКА (При кандидатстване се изисква завършено средно образование)

|
Обучението по специалност „Акушерка“ е в редовна форма с продължителност четири години и се провежда по учебен план и програми, отговарящи на единните държавни изисквания за специалността и на съвременните международни стандарти. Бакалавърската програма предоставя знания, формира умения, навици и компетентности, необходими за изпълнението на самостоятелни или във взаимодействие с лекар дейности при прилагане на комплексни грижи за здравето. Професията включва всички области на проследяване и лечение на неусложнена и усложнена бременност, раждане, следродилен и неонатален период, грижи при гинекологични заболявания, както и поддържане и запазване на репродуктивното здраве.
Завършилите специалността придобиват образователно-квалификационната степен „бакалавър“ и могат да се реализират в лечебни заведения за болнична и извънболнична помощ и др. Възможност за дипломираните акушерки е разкриване на автономни практики за оказване на здравни грижи за различни групи от населението. Обучението по специалността „Акушерка“ се провежда във Факултета по обществено здравеопазване в гр. Варна, както и във филиалите на университета в градовете Сливен, Шумен и Велико Търново.
Учебен план ,
Образуване на бала
|
(При кандидатстване се изисква завършено средно образование)
 |
Обучението по специалност „Медицинска сестра“ е в редовна форма с продължителност четири години и се провежда по учебен план и програми, отговарящи на единните държавни изисквания за специалността и на съвременните международни стандарти. Бакалавърската програма предоставя специфични знания, умения и компетентности за изпълнение на самостоятелни или съвместно с лекар дейности в различни сектори на здравеопазването, прилагайки комплексни грижи за физическото, психическото и социалното здраве. Завършилите специалността придобиват образователно-квалификационната степен „бакалавър“ и могат да се реализират професионално в лечебни заведения за болнична и извънболнична помощ, хосписи, детски ясли, детски градини, училищни здравни кабинети, регионални и национални центрове по обществено здраве и др.
Възможност за дипломираните медицински сестри е и разкриване на автономни практики за оказване на здравни грижи за различни групи от населението.
Обучението по специалността „Медицинска сестра“ се провежда във Факултета по обществено здравеопазване в гр. Варна, както и във филиалите на университета в градовете Сливен, Шумен и Велико Търново.
Учебен план , Образуване на бала |
